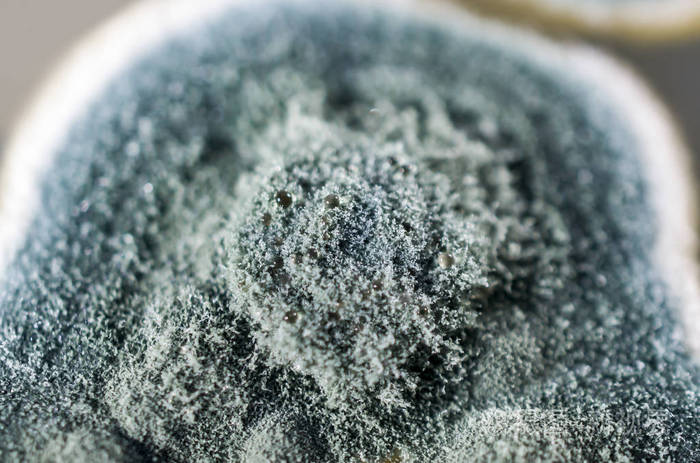
青霉菌菌落在沙氏葡萄糖琼脂上的研究

青霉的菌丝

显微摄影丨青霉菌
图片尺寸1280x720青霉菌的高倍照片
图片尺寸1200x888
你好请问大棚地面青藓上长灰色菌丝,平时大棚比较阴湿,只要下雨就会长
图片尺寸826x1102
马尔尼菲青霉菌
图片尺寸810x1080
青霉菌
图片尺寸1200x1000
显微镜下的青霉菌,有没有被惊艳到?
图片尺寸1080x1076青霉属
图片尺寸801x553
图1-47 青霉菌的菌落,菌丝体.png
图片尺寸553x328
首先是青霉菌种的问题.
图片尺寸451x600
发几个霉菌玉米图
图片尺寸800x600
青霉菌菌落在沙氏葡萄糖琼脂上的研究
图片尺寸700x463
青霉装片
图片尺寸450x370
青霉菌.40倍镜.
图片尺寸500x590
罗克福尔青霉菌照片
图片尺寸612x408
青霉菌
图片尺寸700x1245生长在琼脂板上的青霉菌.购买链接
图片尺寸5184x3456
青霉菌
图片尺寸1080x810
青霉菌.ppt
图片尺寸1152x864
面包发霉与面包霉菌病原青霉的特写镜头照片
图片尺寸450x300sabouraud dextrose琼脂上青霉菌菌落
图片尺寸1200x795